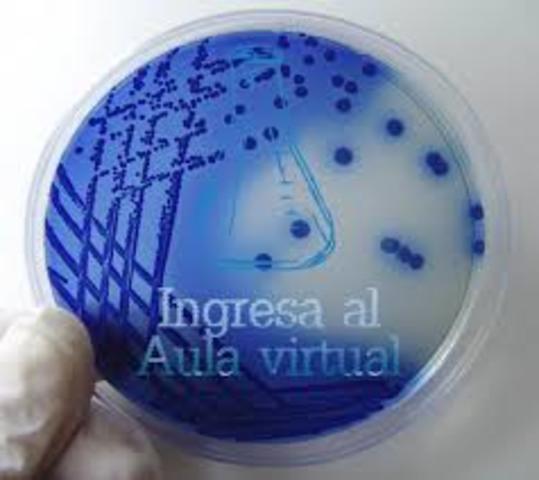
definición aceptada  de la educación a distancia

-
-
-
-
-
-
Utilizando páginas web, foros asincrónicos de discusión y correo electrónico.
-
en desempeño académico, actitud y la retención y deserción del estudiante.
-
-
Generalmente se utilizan tecnologías que permiten la transmisión sincrónica (en tiempo real, en vivo y espontáneas) de audio y/o vdeo.
-
Plan projects on a visual timeline
Map milestones, phases, deadlines, and key events in one place so the sequence is easier to see and share. Timetoast is a timeline maker for work, school, research, and stories.